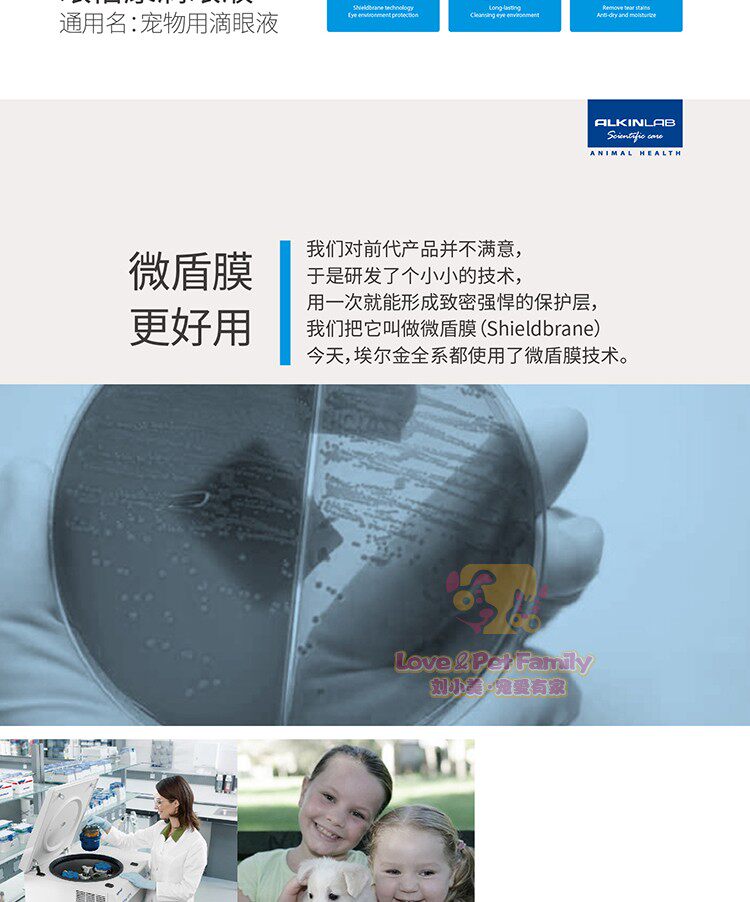

Капли для глаз, кошачий глаз, 10 мл

Цена: 846руб. (¥40)
Артикул: 575151699118
Вес товара: ~0.7 кг. Указан усредненный вес, который может отличаться от фактического. Не включен в цену, оплачивается при получении.
Описание товараPHA+PGltZyBhbGlnbj0iYWJzbWlkZGxlIiBzcmM9Imh0dHBzOi8vaW1nLmFsaWNkbi5jb20vaW1nZXh0cmEvaTIvMTE1NTYwMDAvTzFDTjAxUkMzNEFTMXVDMnZ4Rm9JVU1fISExMTU1NjAwMC5qcGciIHN0eWxlPSJtYXgtd2lkdGg6IDc1MC4wcHg7Ij48aW1nIGFsaWduPSJhYnNtaWRkbGUiIHNyYz0iaHR0cHM6Ly9pbWcuYWxpY2RuLmNvbS9pbWdleHRyYS9pMS8xMTU1NjAwMC9PMUNOMDF0Y2h1ek8xdUMyd09MYTZ1c18hITExNTU2MDAwLmpwZyIgc3R5bGU9ImZvbnQtc2l6ZTogMTIuMHB4O21heC13aWR0aDogNzUwLjBweDsiPjxpbWcgYWxpZ249ImFic21pZGRsZSIgc3JjPSJodHRwczovL2ltZy5hbGljZG4uY29tL2ltZ2V4dHJhL2k0LzExNTU2MDAwL08xQ04wMWt0VTRCRzF1QzJ3U2ZRMlJ1XyEhMTE1NTYwMDAuanBnIiBzdHlsZT0iZm9udC1zaXplOiAxMi4wcHg7bWF4LXdpZHRoOiA3NTAuMHB4OyI+PGltZyBhbGlnbj0iYWJzbWlkZGxlIiBzcmM9Imh0dHBzOi8vaW1nLmFsaWNkbi5jb20vaW1nZXh0cmEvaTEvMTE1NTYwMDAvTzFDTjAxYzJrNXp5MXVDMndTNnFWRDJfISExMTU1NjAwMC5qcGciIHN0eWxlPSJmb250LXNpemU6IDEyLjBweDttYXgtd2lkdGg6IDc1MC4wcHg7Ij48aW1nIGFsaWduPSJhYnNtaWRkbGUiIHNyYz0iaHR0cHM6Ly9pbWcuYWxpY2RuLmNvbS9pbWdleHRyYS9pMy8xMTU1NjAwMC9PMUNOMDFLY2xVZEYxdUMyd1RXZWRubF8hITExNTU2MDAwLmpwZyIgc3R5bGU9ImZvbnQtc2l6ZTogMTIuMHB4O21heC13aWR0aDogNzUwLjBweDsiPjxpbWcgYWxpZ249ImFic21pZGRsZSIgc3JjPSJodHRwczovL2ltZy5hbGljZG4uY29tL2ltZ2V4dHJhL2kyLzExNTU2MDAwL08xQ04wMTN0NlgwVjF1QzJ3VDRJSzFLXyEhMTE1NTYwMDAuanBnIiBzdHlsZT0iZm9udC1zaXplOiAxMi4wcHg7bWF4LXdpZHRoOiA3NTAuMHB4OyI+PGltZyBhbGlnbj0iYWJzbWlkZGxlIiBzcmM9Imh0dHBzOi8vaW1nLmFsaWNkbi5jb20vaW1nZXh0cmEvaTMvMTE1NTYwMDAvTzFDTjAxbVJGcDQzMXVDMndOOTg0dmhfISExMTU1NjAwMC5qcGciIHN0eWxlPSJmb250LXNpemU6IDEyLjBweDttYXgtd2lkdGg6IDc1MC4wcHg7Ij48aW1nIGFsaWduPSJhYnNtaWRkbGUiIHNyYz0iaHR0cHM6Ly9pbWcuYWxpY2RuLmNvbS9pbWdleHRyYS9pNC8xMTU1NjAwMC9PMUNOMDFCQ2ZkTzkxdUMyd1BsaXZUd18hITExNTU2MDAwLmpwZyIgc3R5bGU9ImZvbnQtc2l6ZTogMTIuMHB4O21heC13aWR0aDogNzUwLjBweDsiPjxpbWcgYWxpZ249ImFic21pZGRsZSIgc3JjPSJodHRwczovL2ltZy5hbGljZG4uY29tL2ltZ2V4dHJhL2k0LzExNTU2MDAwL08xQ04wMW5BeVJqMzF1QzJ3UGxndW5aXyEhMTE1NTYwMDAuanBnIiBzdHlsZT0iZm9udC1zaXplOiAxMi4wcHg7bWF4LXdpZHRoOiA3NTAuMHB4OyI+PGltZyBhbGlnbj0iYWJzbWlkZGxlIiBzcmM9Imh0dHBzOi8vaW1nLmFsaWNkbi5jb20vaW1nZXh0cmEvaTMvMTE1NTYwMDAvTzFDTjAxNW5XMUtiMXVDMndQbGo4MG5fISExMTU1NjAwMC5qcGciIHN0eWxlPSJmb250LXNpemU6IDEyLjBweDttYXgtd2lkdGg6IDc1MC4wcHg7Ij48L3A+
Продавец:劉小美寵愛YOU家
Рейтинг:

Всего отзывов:0
Положительных:0
Добавить в корзину
- Информация о товаре
- Фотографии